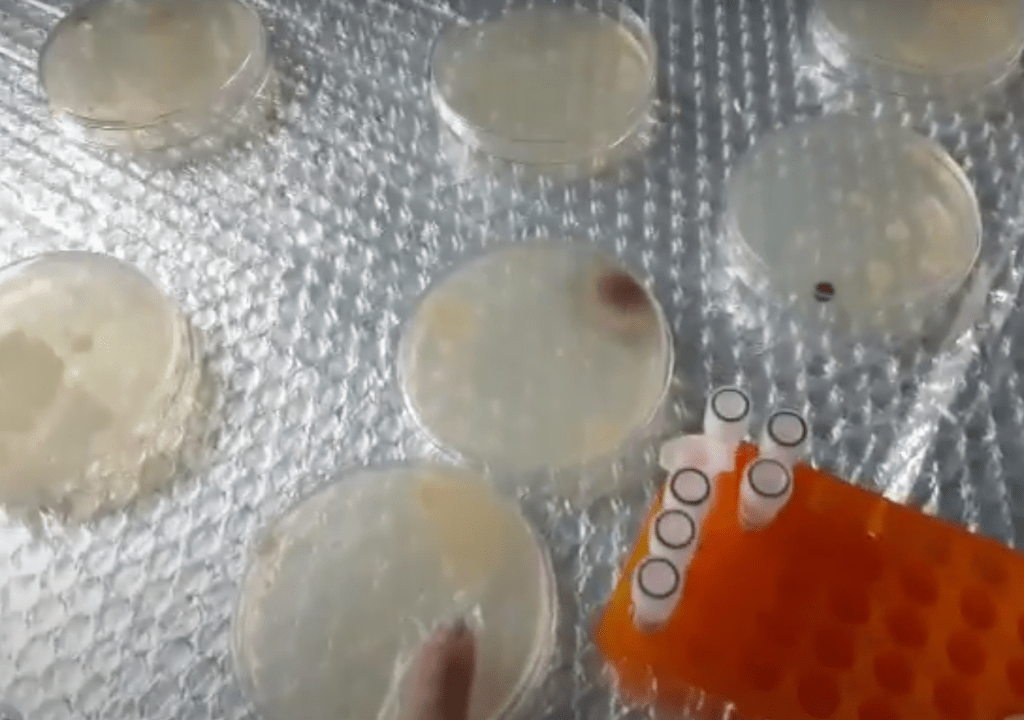
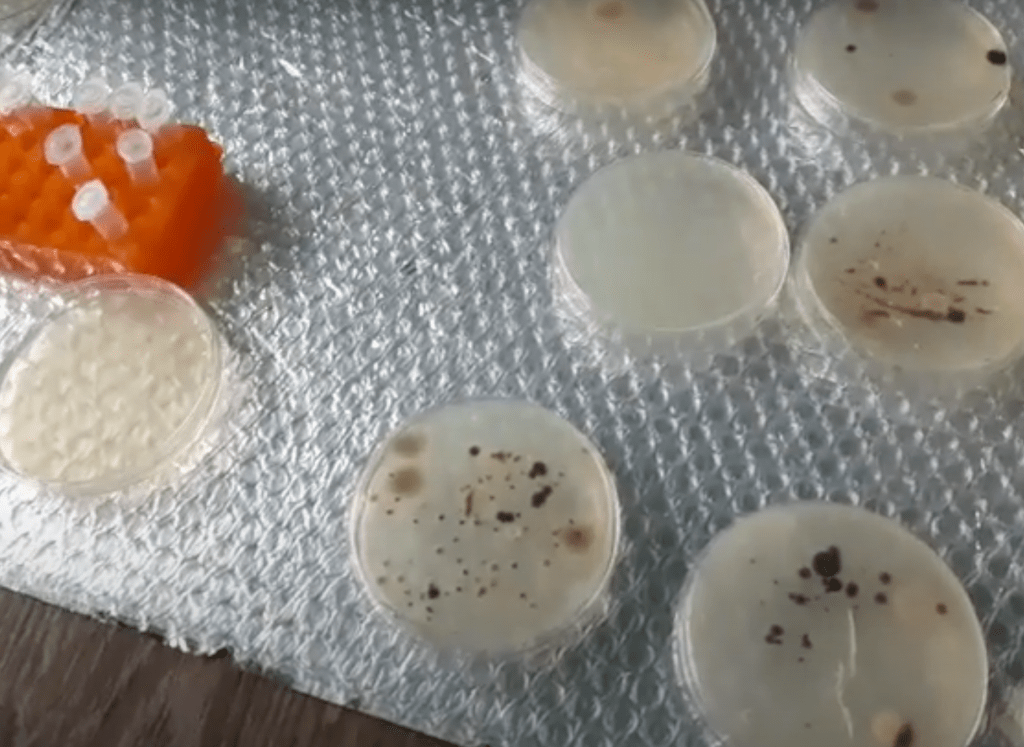
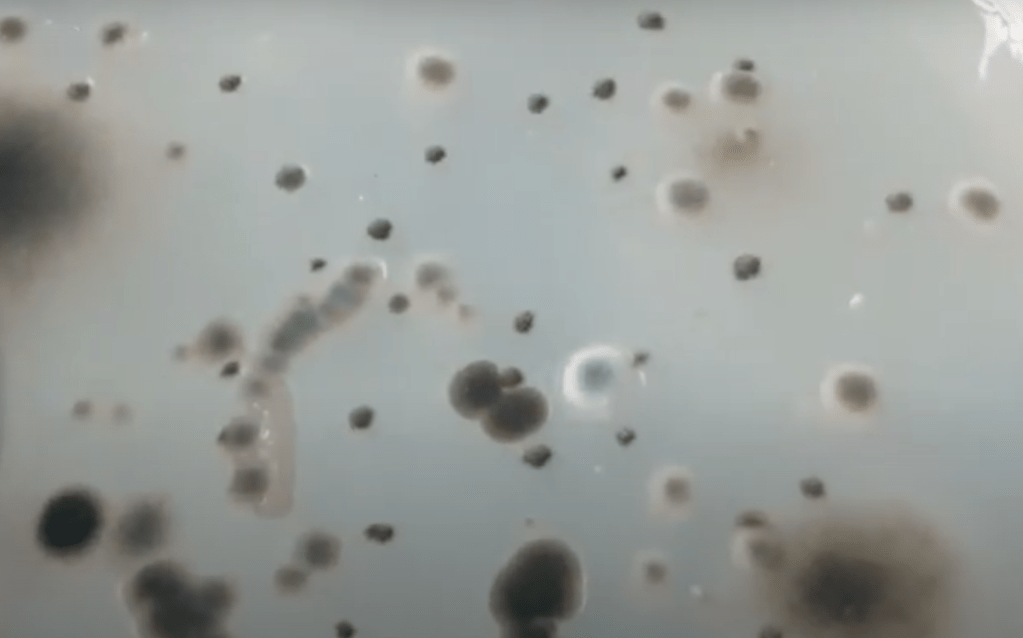
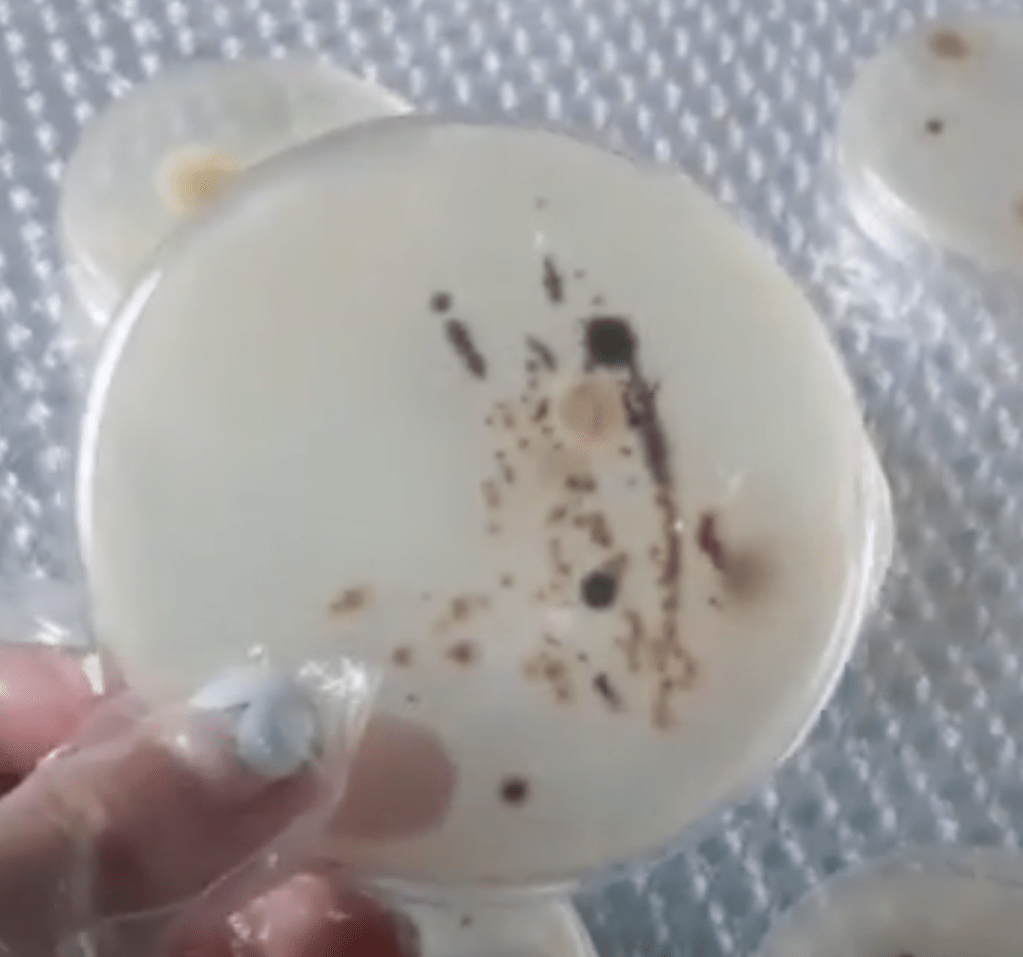
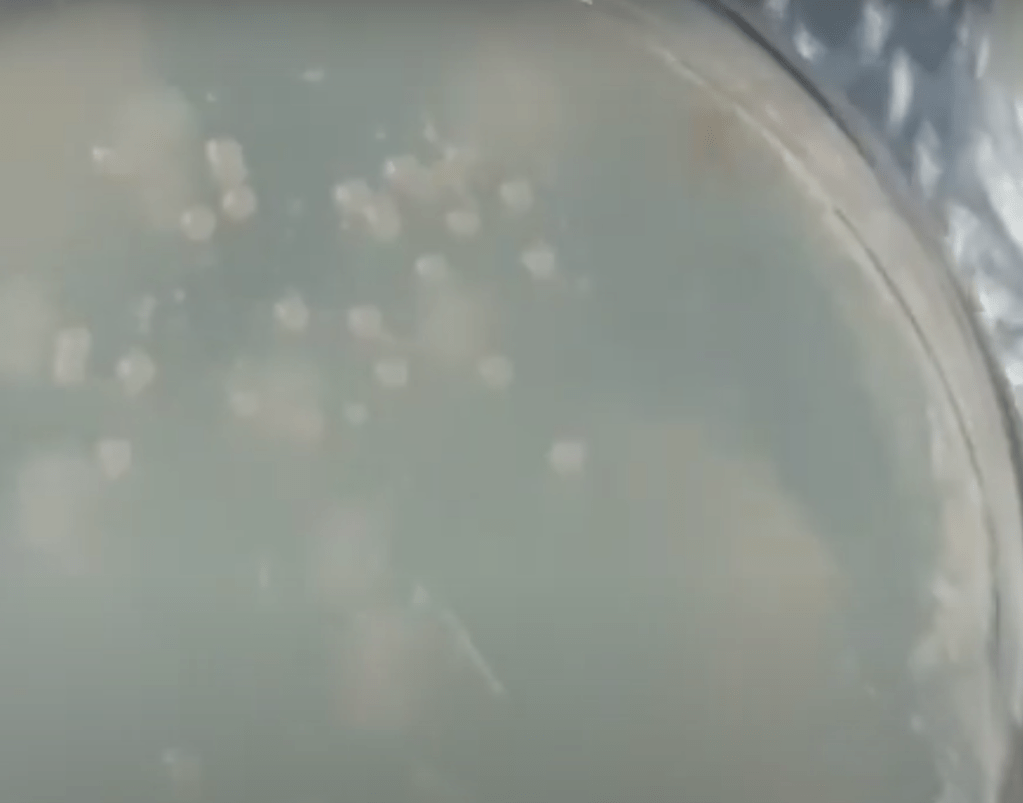

I was able to see much more substantial growth after another 24 hours since my first check-in with the two Agar plates. The bacteria in the LB Agar plates grew even more than the results the day before, and I was glad that my first goal of this experiment was successful: cultivating a lot of bacteria on my LB Agar plates.
There still was more mold growing on the LB Agar plates, though.. An example of this can be the fuzzy brown mold and the black circular mold. I’m really curious what these molds are and how they actually formed. I’m also incredibly curious if CRISPR editing on mold is possible.
Then, moving onto the LB Strep/Kan/Arabinose Agar plates.
I’m still quite disappointed with the results of the LB Strep/Kan/Arabinose Agar plates, because most of the plates did not show the results I originally expected. According to the user manual, there are supposed to be tiny white dots dispersed across the plate. However, these were the results I “obtained”:
You can definitely see a ton of dark mold..
The sizes and degree of the molds were very various. While some were small and light-colored, some were extremely huge and dark colored.
This was another mold growing in the LB Strep/Kan/Arabinose Agar plate, but it was of a different color and size!

Then, a MIRACLE happened!!!!!!
I’m not fully sure if this is mold or if it actually is the correct bacteria as shown in the user manual, but I noticed a LB Strep/Kan/Arabinose Agar plate with dispersed white dots, and I was extremely happy!!
This is what the plate looks like:
I’m extremely happy and proud of myself for successfully achieving this experiment, despite this being my first time!!
-Joanna Kim, August 12th, 2020, 1:19 AM KST